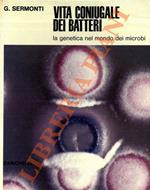

IBS.it, l'altro eCommerce
L’articolo è stato aggiunto alla lista dei desideri
Libri usati di Giuseppe Sermonti
Reparti
Offerte
Disponibilità
Prezzo (€)
Autori
Editori e marche
Vedi tutti
Mostra meno
Collane e linee
Venditore
Vedi tutti
Mostra meno
Tutti i risultati (11)
La mela di adamo e la mela di newton
Venditore: Libro di Faccia
Rusconi Editore,
1974
Libri Vintage | Varia
-20%
11,50 €
9,20 €
La luna nel bosco. Saggio sull'origine della scimmia
Venditore: Libreria Catap
Rusconi Libri,
1985
Libri Vintage | Scienze naturali
20,00 €
La mela di Adamo e la mela di Newton
Venditore: Libreria sottomarina
Rusconi Libri,
1974
Libri Vintage | Narrativa italiana
14,90 €
Dimenticare Darwin. Ombre sull'evoluzione
Venditore: Multibook
Rusconi Libri,
1999
Libri Vintage | Storia e archeologia
50,00 €
mela di Adamo e la mela di Newton
Venditore: Libreria Tara
Rusconi Libri,
1974
Libri Vintage | Scienze naturali
11,00 €
Scienziati nella tempesta. Profeti e professori
Venditore: Biblioteca di Babele
DR, Di Renzo editore,
2003
Libri Vintage | Scienze naturali
8,00 €
La mela di Adamo e la mela di Newton
Venditore: Librisaggi
(altre 1 offerte)
Nova Scripta,
2006
Libri Vintage | Religione e spiritualità
11,00 €
Vita coniugale dei batteri. La genetica nel mondo dei microbi
Venditore: Libreria Piani
Zanichelli,
1972
Libri Vintage | Varia
25,00 €
Vita coniugale dei batteri
Venditore: Biblioteca di Babele
Zanichelli,
1972
Libri Vintage | Scienze naturali
15,00 €
Dopo Darwin. Critica all'evoluzionismo
Venditore: Libreria Piani
Rusconi Libri,
1980
Libri Vintage | Varia
35,00 €
Informazioni sull’ordinamento
Vengono mostrati per primi i prodotti che rispondono a questi criteri: rilevanza rispetto alla ricerca, dati di venduto, disponibilità, data di pubblicazione, tipologia di prodotto, personalizzazione ad eccezione delle sponsorizzazioni.